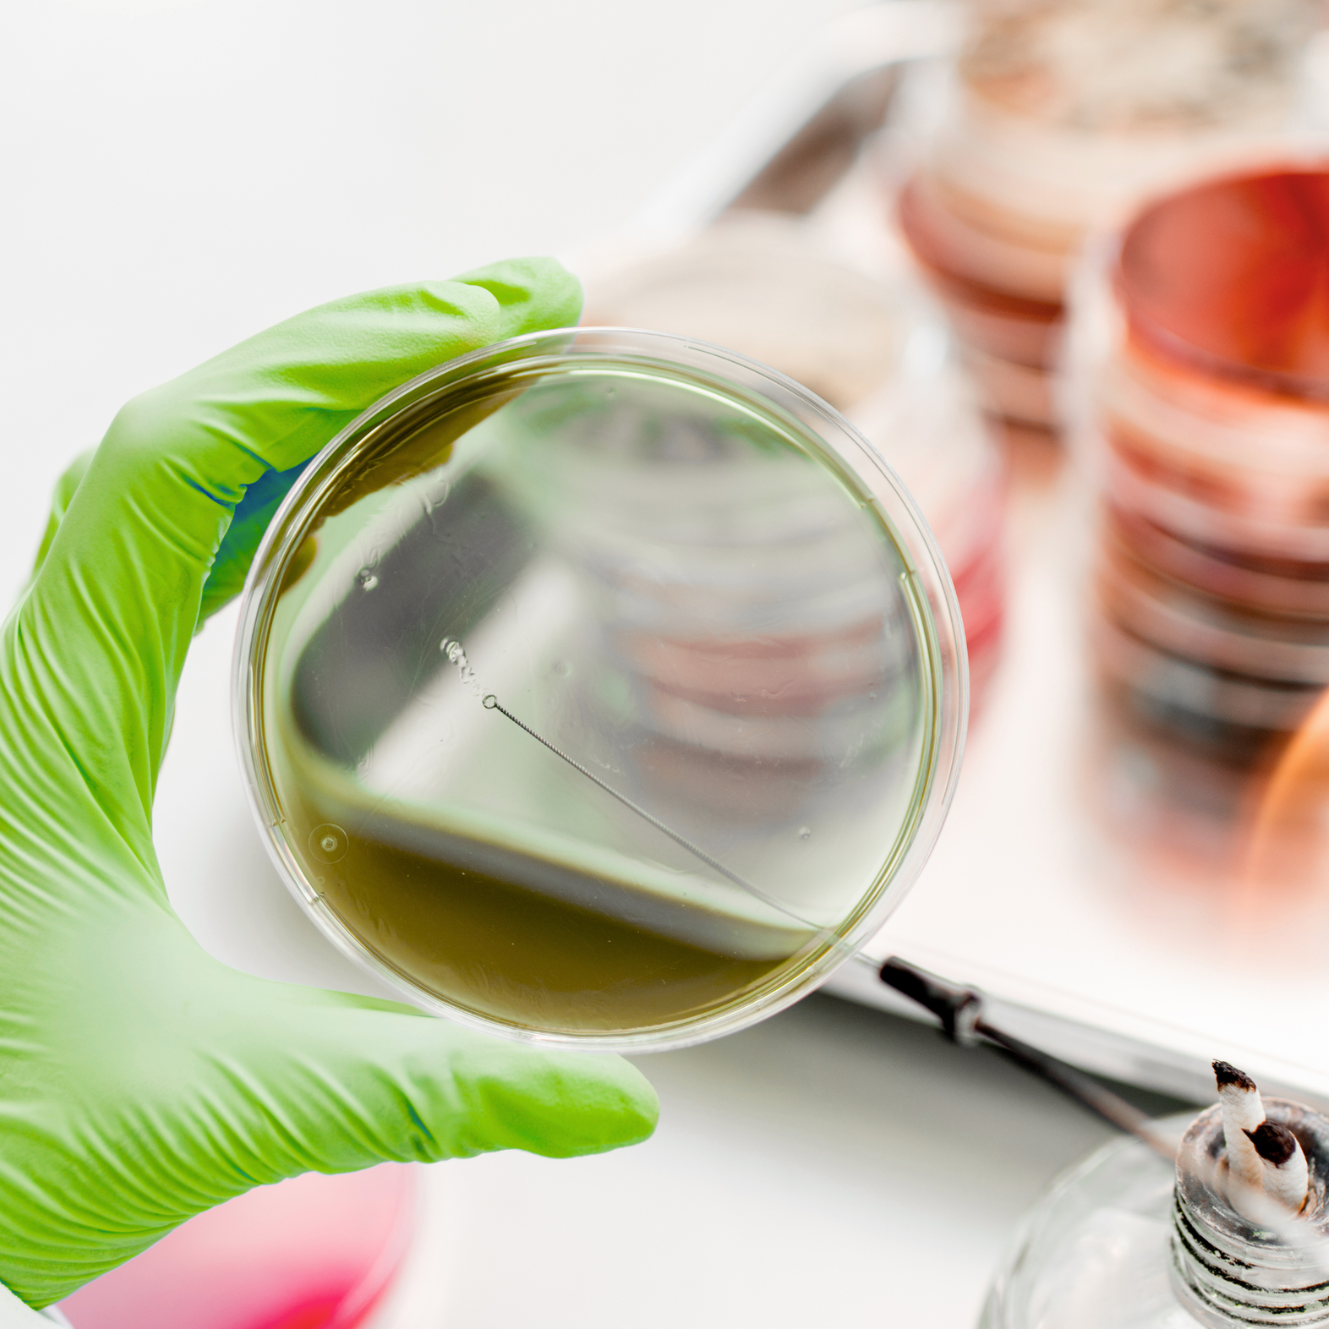
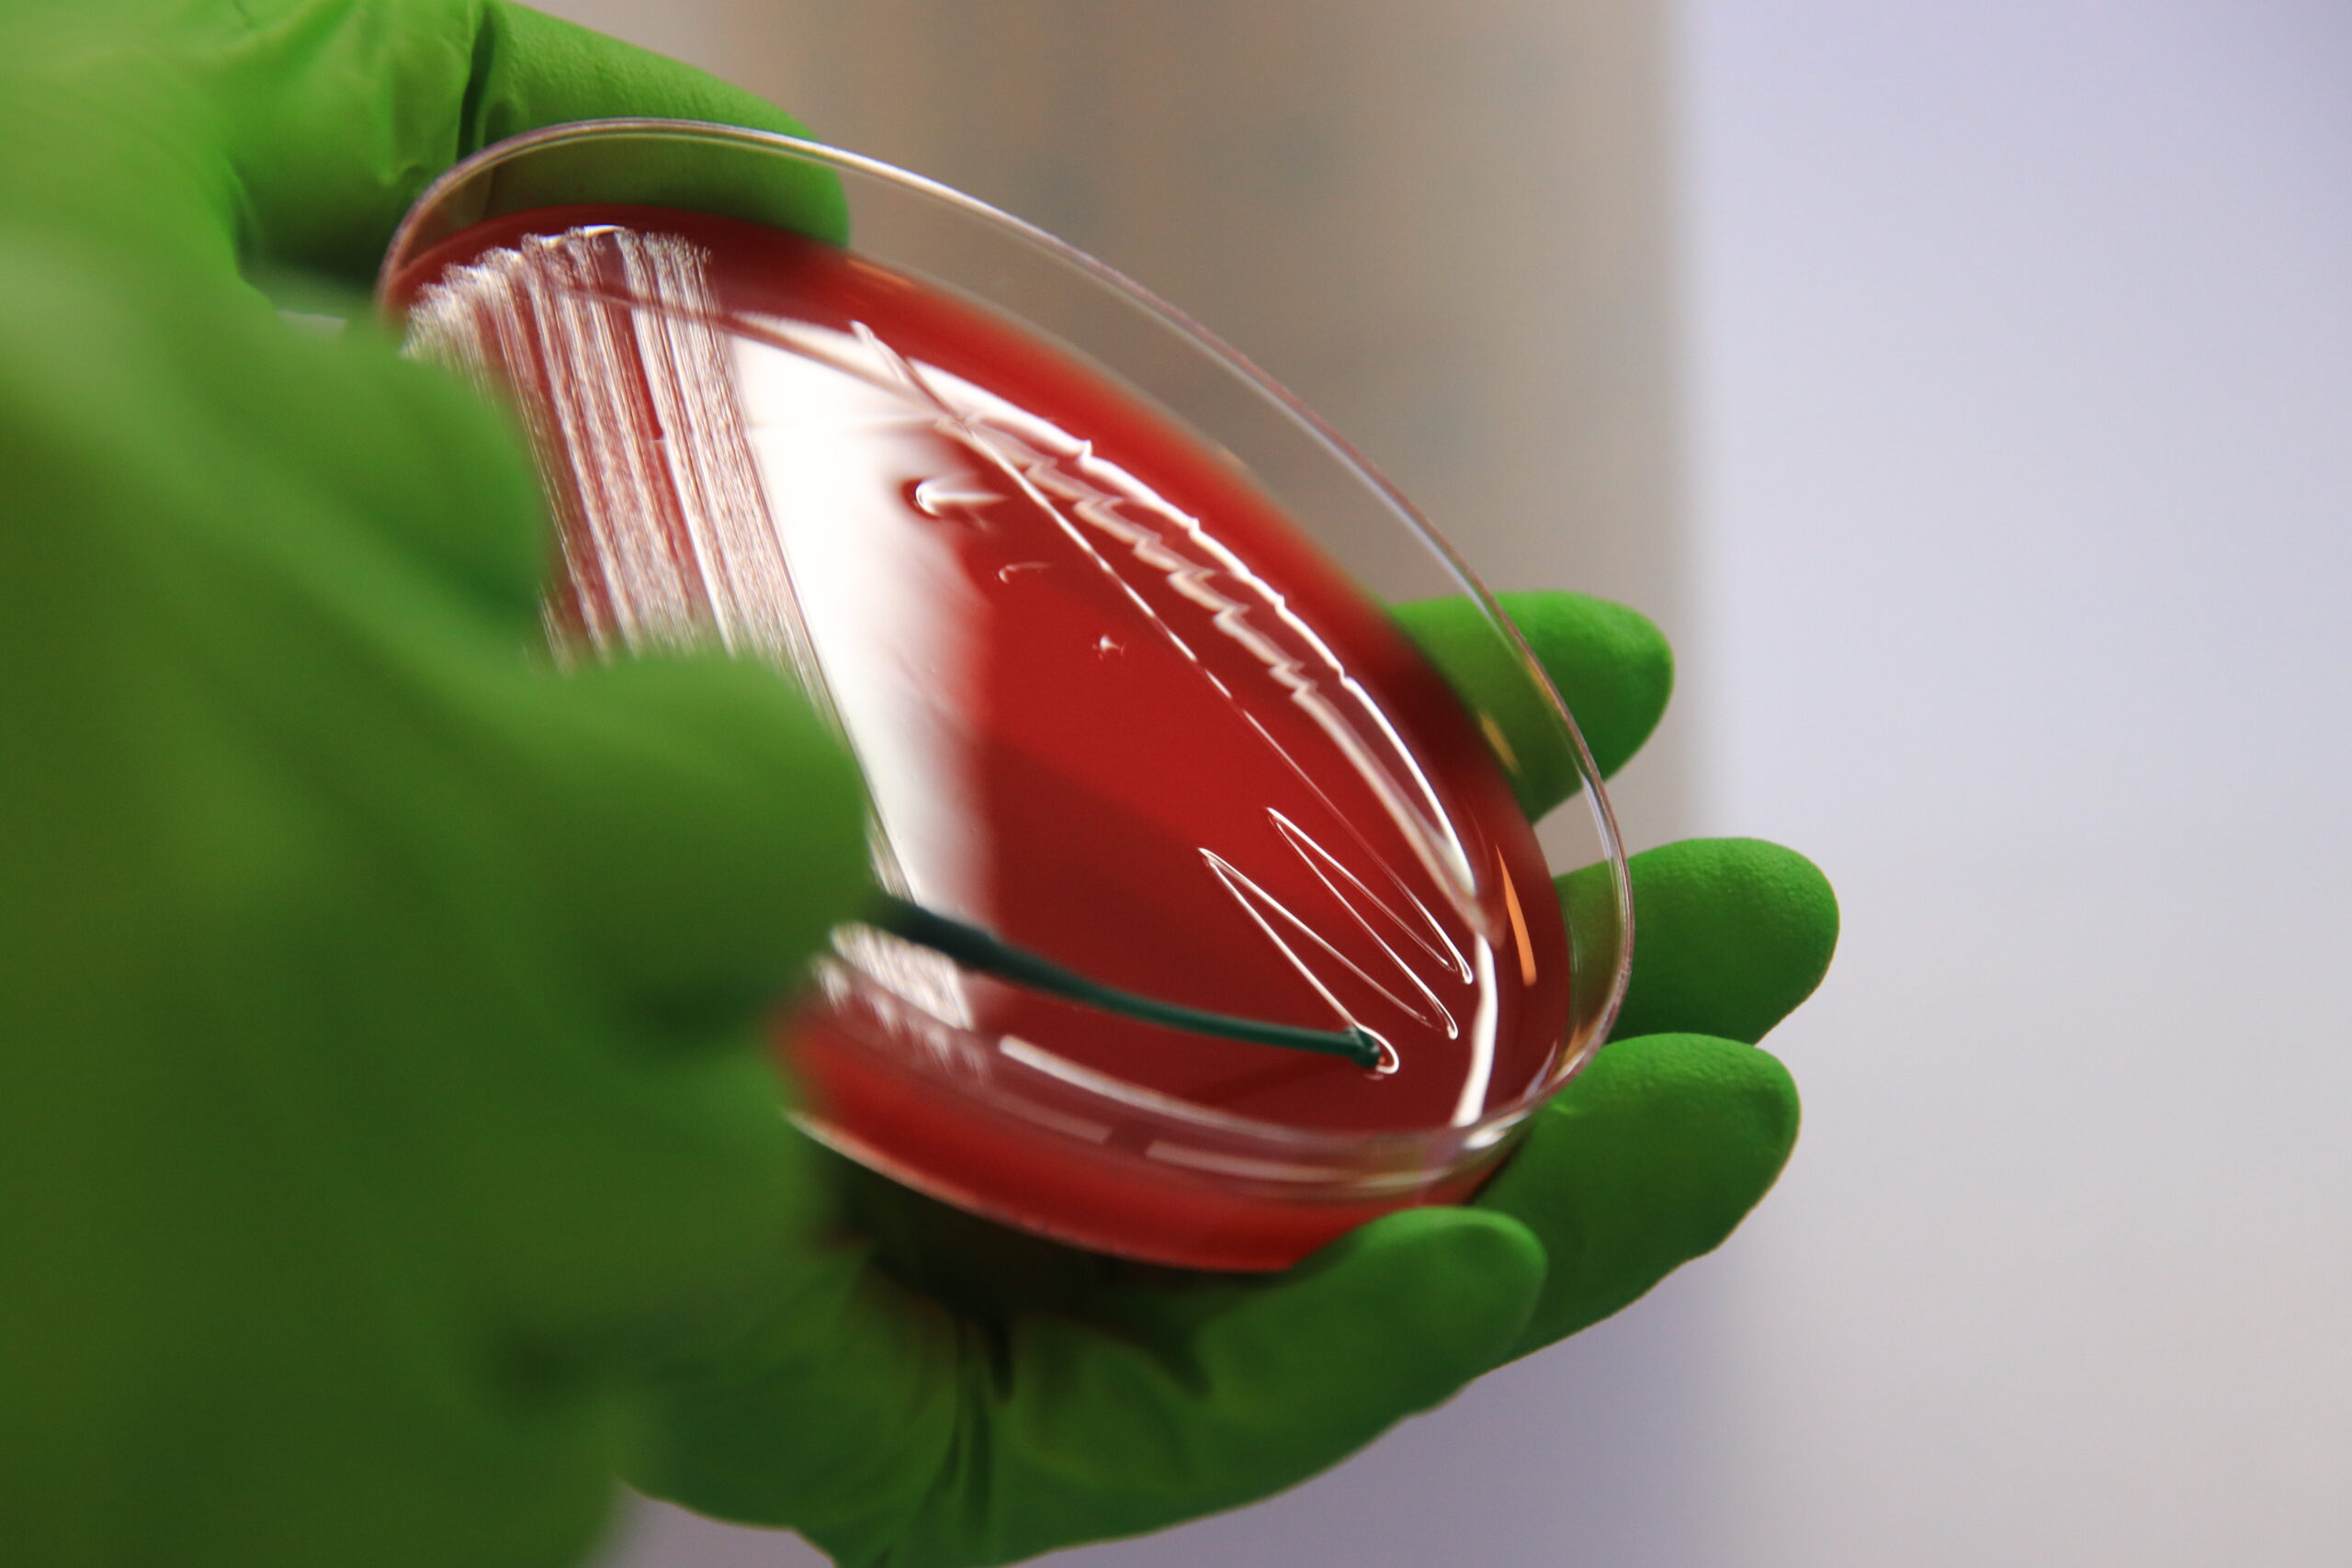
diagnostics

Poulpharm is an animal health Contract Research Organization (CRO) and diagnostic service provider, and a member of the SAS Global Group.
The Group’s integrated business model provides the animal health industry with streamlined research, diagnostics and project management solutions, combining scientific expertise with an extensive network of specialized laboratories, research facilities and strategic partners to support innovation in animal health. Core services include preclinical and clinical trials, virology, bacteriology and vaccine evaluation.
Facilities are located in Europe, Asia and Latin America, and operations can be conducted under GLP, GCP and ISO 17025 accreditation.